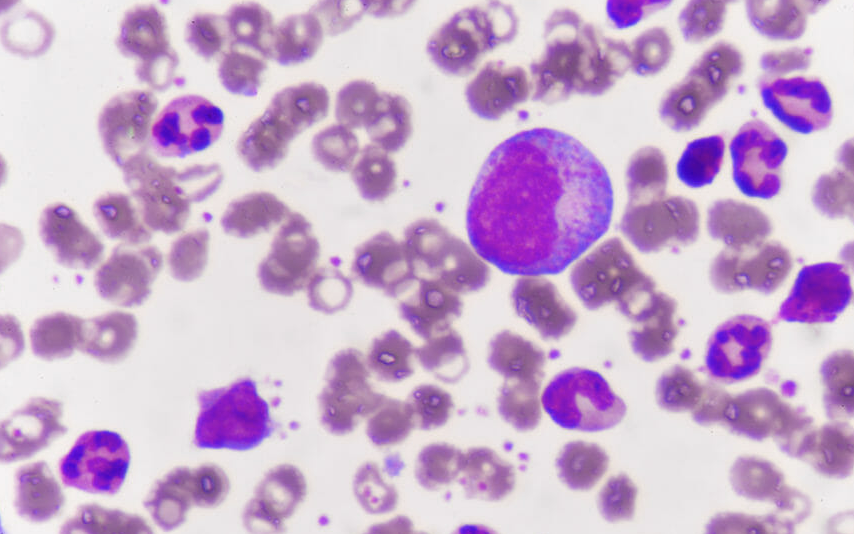

이슈있소
만성골수성백혈병 증상, 원인, 표적치료제 본문
만성골수성백혈병은 영화나 드라마 등에서 불치병으로 인식되는 주요주제 중 하나이다. 하지만 표적치료제가 개발되면서 꾸준히 치료받으면 생존율이 90%에 이를 만큼 예후가 좋은 암이기도 하다.
1. 대부분 건강검진 시 우연히 발견
만성골수성백혈병은 특정유전자 이상(필라델피아염색체의 출현)으로 혈액세포가 과다증식하고 백혈구와 혈소판 수가 늘어나면서 천천히 진행되는 혈액암이다. 대부분 건강검진에서 백혈구수치 증가로 우연히 발견되며 약 60%가 무증상이다. 단 진행정도에 따라 ▲피로감 ▲어지럼증 ▲두통 ▲체중감소 ▲발열 ▲야간발한 ▲체중감소 ▲비장비대로 인한 좌측 상복부 불편감 등의 증상이 나타날 수 있다.
만성골수성백혈병의 원인은 아직 명확히 밝혀지지 않았다. 환경적 요인에 대한 언급도 있지만 마찬가지로 증명되지 않았다. 단 장시간 다량의 방사선에 노출된 경우 만성골수성백혈병 유병률을 높일 수 있다는 연구결과가 있다. 하지만 보통의 진료나 치료와는 관련이 없다.
만성골수성백혈병은 필라델피아염색체(9번 염색체와 22번 염색체의 일부유전자가 전위) 출현으로 생긴 ‘BCR-ABL1’이라는 유전자로 인한 질환이며 표적치료제가 개발돼 치료예후가 매우 좋다. 표적치료제는 기존항암제와 달리 정상세포를 거의 파괴하지 않아 부작용이 적다. 약 90%의 환자가 꾸준히 복용하면 일상생활이 가능하며 기대수명도 일반인과 비슷하다.
표적치료제가 나온 2000년대 이후 기능적 완치(유전자변이가 거의 검출되지 않을 정도로 잘 조절된 상태, 약 복용 중단 및 유전자변이가 검출되지 않는 수준)를 목표로 치료하고 있다. 현재 약 25~30%의 환자는 기능적 완치를 기대할 수 있으며 나머지 환자도 약을 복용하면서 정상적인 일상생활을 하고 있다. 또 만성골수성백혈병은 감염성이나 유전성질환이 아니며 대부분 후천적으로 발생한다.
2. 동종 조혈모세포이식은 필수?(X)
동종 조혈모세포이식은 만성골수성백혈병 치료에 있어 필수는 아니며 이를 시행하는 환자는 10% 미만이다. 최근 4세대 표적치료제가 개발돼 향후 동종 조혈모세포이식환자는 더 줄어들 것으로 예상된다. 단 급성기에 진단되거나 경구약에 반응이 없는 환자, 약물내성을 보이는 환자 등은 동종 조혈모세포이식을 고려할 수 있다.
3. 예방 또는 조기진단 가능하다?(X)
만성골수성백혈병은 예방이나 조기진단이 어렵다. 다행히 진행정도가 느리고 급성기나 가속기 진행까지 3~5년 정도 소요돼 매년 건강검진에서 혈액검사를 통해 발견할 수 있다. 단 2년에 한 번씩 하는 국가검진에서는 백혈구, 혈소판수치를 알 수 없어 혈액검사가 필요하다.
대체로 증상이 모호하고 특이점이 없어 증상만으로는 확인하기 어렵다. 단 특별한 원인 없이 비정상적으로 백혈구가 증가한 경우 의심할 수 있으며 이는 간단한 혈액검사만으로도 확인 가능하다.
4. 초기치료반응·순응도 중요
만성골수성백혈병을 치료 중인 환자나 보호자들의 가장 큰 오해 중 하나가 표적치료제에 대한 부작용이다.
만성골수성백혈병은 주로 무증상이거나 경미한 증상을 보이지만 명확한 암종 중 하나다. 표적치료 시 초기에 치료제로 인한 부작용이 발생할 수 있다. 환자에 맞는 약을 찾는 과정은 짧으면 6개월에서 길게는 1년까지 소요된다. 만성골수성백혈병은 초기치료반응과 치료순응도가 중요한 만큼 그 과정에서 발생하는 부작용과 불편을 견딜 수 있어야 한다.
'트렌딕, 앎을 선도하다' 카테고리의 다른 글
| 국화차 효능 효과, 부작용 & 건조 국화차 만들기 만드는 방법 (0) | 2023.09.27 |
|---|---|
| 2023 2024 독감 인플루엔자 백신 국가예방접종 대상, 시기, 장소 (0) | 2023.09.27 |
| 탕후루 칼로리 열량 & 자주 먹으면 위험한 안 좋은 이유 (0) | 2023.09.27 |
| 수면의 기능과 역할 & 렘수면, 비렘수면, 반구수면 (0) | 2023.09.27 |
| 아이 아기 소아 응급상황 & 구토, 발열, 열성경련 대처법 (0) | 2023.09.27 |